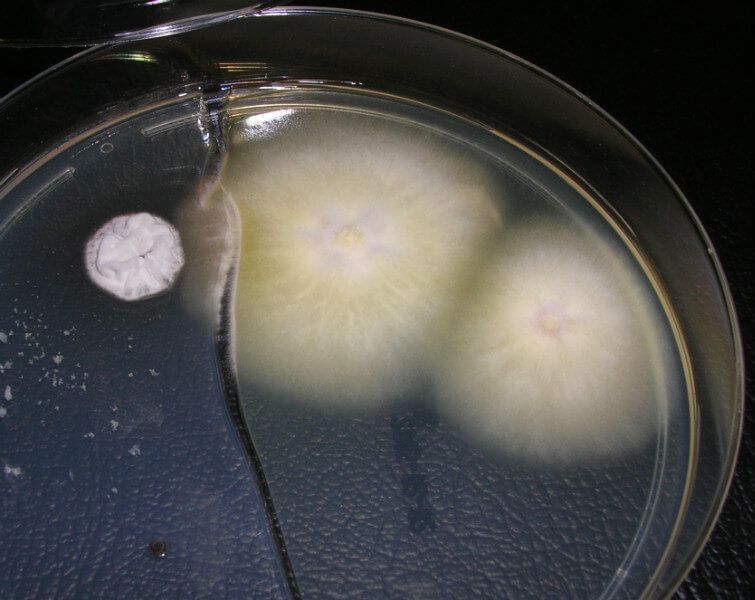
slide

In unserem Speziallabor führen wir schwerpunktmässig die Pilzuntersuchungen durch zur Abklärung zahlreicher «mykologisch», d.h. pilzbedingter Haut- und Nagel-, gelegentlich auch Haarveränderungen. Mit Mikroskop und Kulturschalen können die sogenannten Dermatophyten («Fadenpilze»), Schimmel oder Hefepilze als mögliche Verursacher erkannt und die Hauterscheinungen somit korrekt behandelt werden.
Zur Qualitätssicherung nimmt das Labor regelmässig an dem von der Deutschen Dermatologischen Gesellschaft und Deutschen Mykologischen Gesellschaft jährlich zusammen durchgeführten «Ringversuch zur mykologischen Qualitätssicherung in der Dermatologie» erfolgreich teil.
Um Haarerkrankungen und Haarausfall fachgerecht einschätzen zu können, führen wir dazu – wo nötig – auch die mikroskopische Haarwurzelanalyse («Trichogramm») in unserem Labor durch.
Ausserdem betreiben wir die mikroskopischen Untersuchungen zur Erkennung von Geschlechtserkrankungen mittels Abstrichuntersuchungen sowie einfache Urinanalysen.
Weiterführende diagnostische Abklärungen, z.B. Blut, Stuhl, Bakterienabstriche, geben wir bei einem grossen medizinischen Labor in Auftrag, welches stets zuverlässig mit uns zusammenarbeitet.